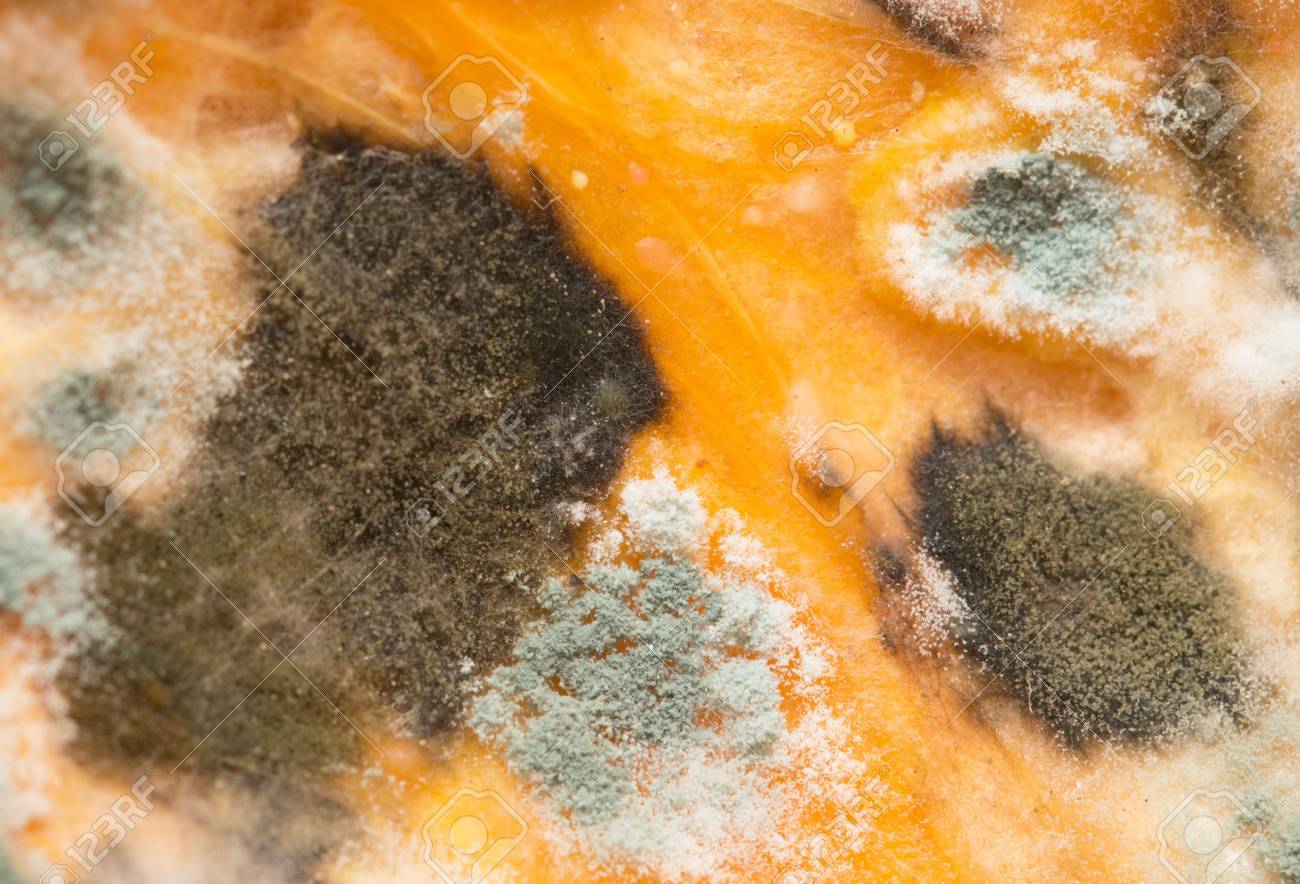
etiam-dictum-ipsum-a-felis

Download
Close
Автор:
id:
Ключевые слова:
aerobic, aspergillus, background, bacteria, bad, biology, bread, close, closeup, contaminate, decay, disappointing, food, fungal, fungi, fungus, fuzzy, green, macro, microbes, mildew, mold, mould, mouldy, natural, nobody, old, poor, rotten, spoilage, spores, substance, up, waste, white,





